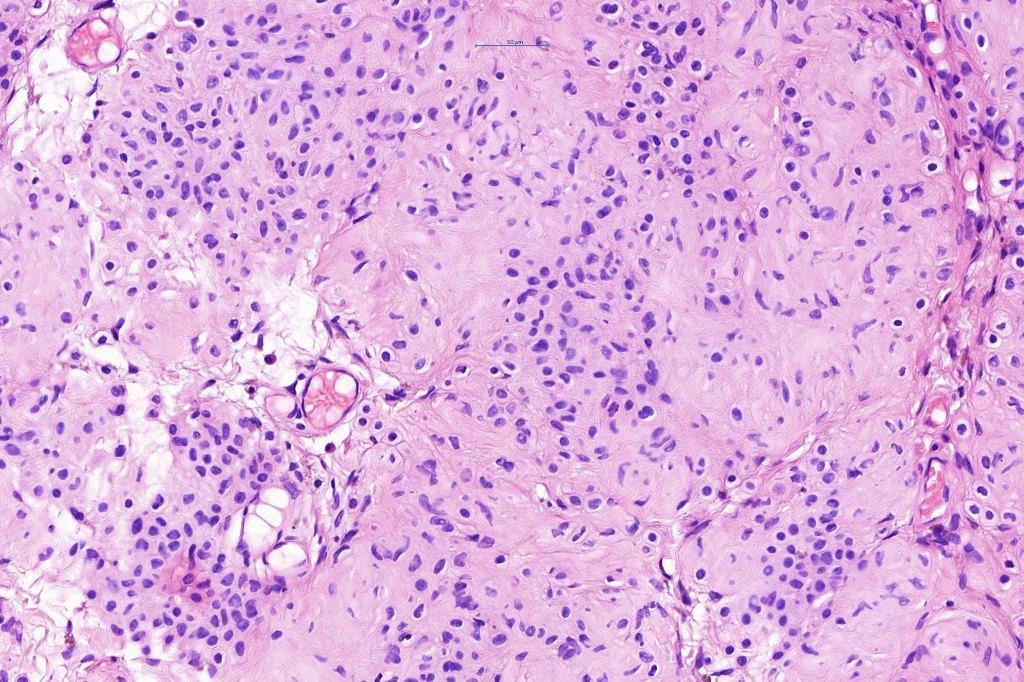
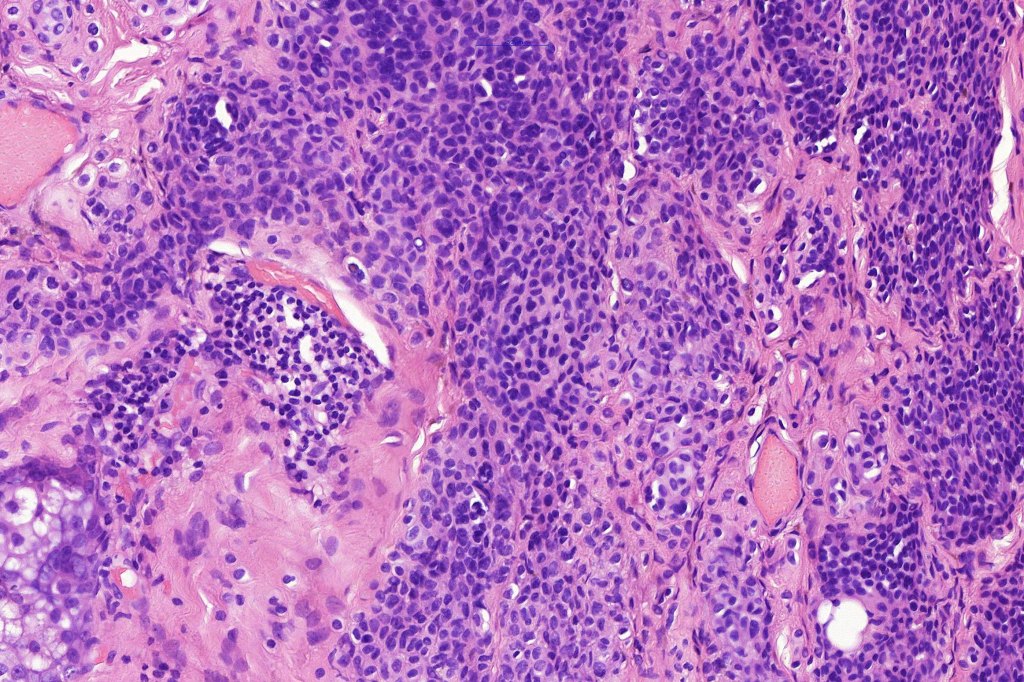
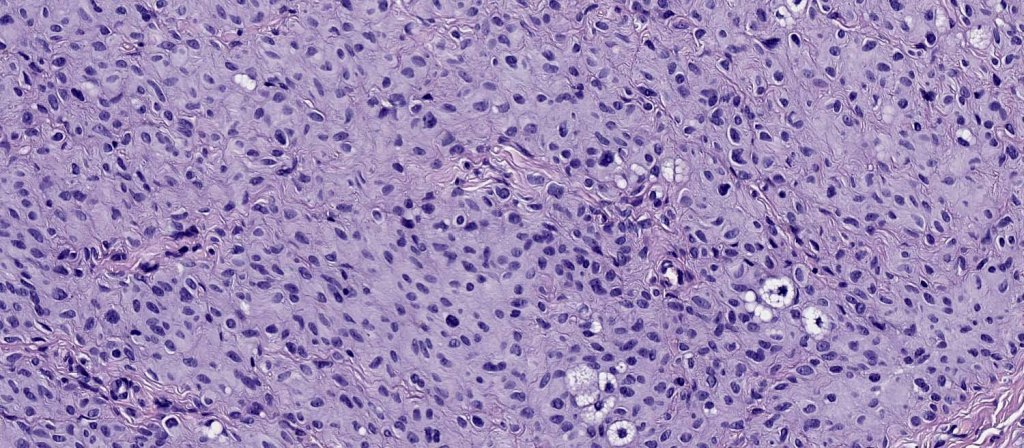

Balloon cell nevus represents the benign counterpart of balloon cell melanoma.
Clinical features
. Most common in first 3 decades
. Head & neck > trunk & extremities although any site may be affected including the mucosae
. No sex predilection
Histological features
.Balloon cell change is most often seen in banal melanocytic nevi but it has also rarely been described in cellular blue nevus, dysplastic nevus, combined nevus, halo nevus & Spitz nevus. Lesions with <50% of balloon cells are sometimes described as nevi with balloon cells. Nevi with >50% balloon cells are described as balloon cell nevus.
.Balloon cell nevs genrally has uniform, hyperchromatic nuceli (as opposed to the vesicular nuclei with prominent nucleoli) seen in melanoma. Mitoses are absent.(In my experience, balloon cell melanoma is more common than balloon cell nevus).
. In some balloon cell nevi, the microvesicles may result in nuclear scalloping reminiscent of a sebaceous tumor. In cases where there is real doubt, immunohistochemistry (S100), SOX10) will resolve the problem.
The importance of the entity is that it must always be distinguished from balloon cell melanoma. All cases should be scrutinized very carefully for pleomorphism and mitotic activiy before rendering a diagnosis of balloon cell nevus.

Leave a comment